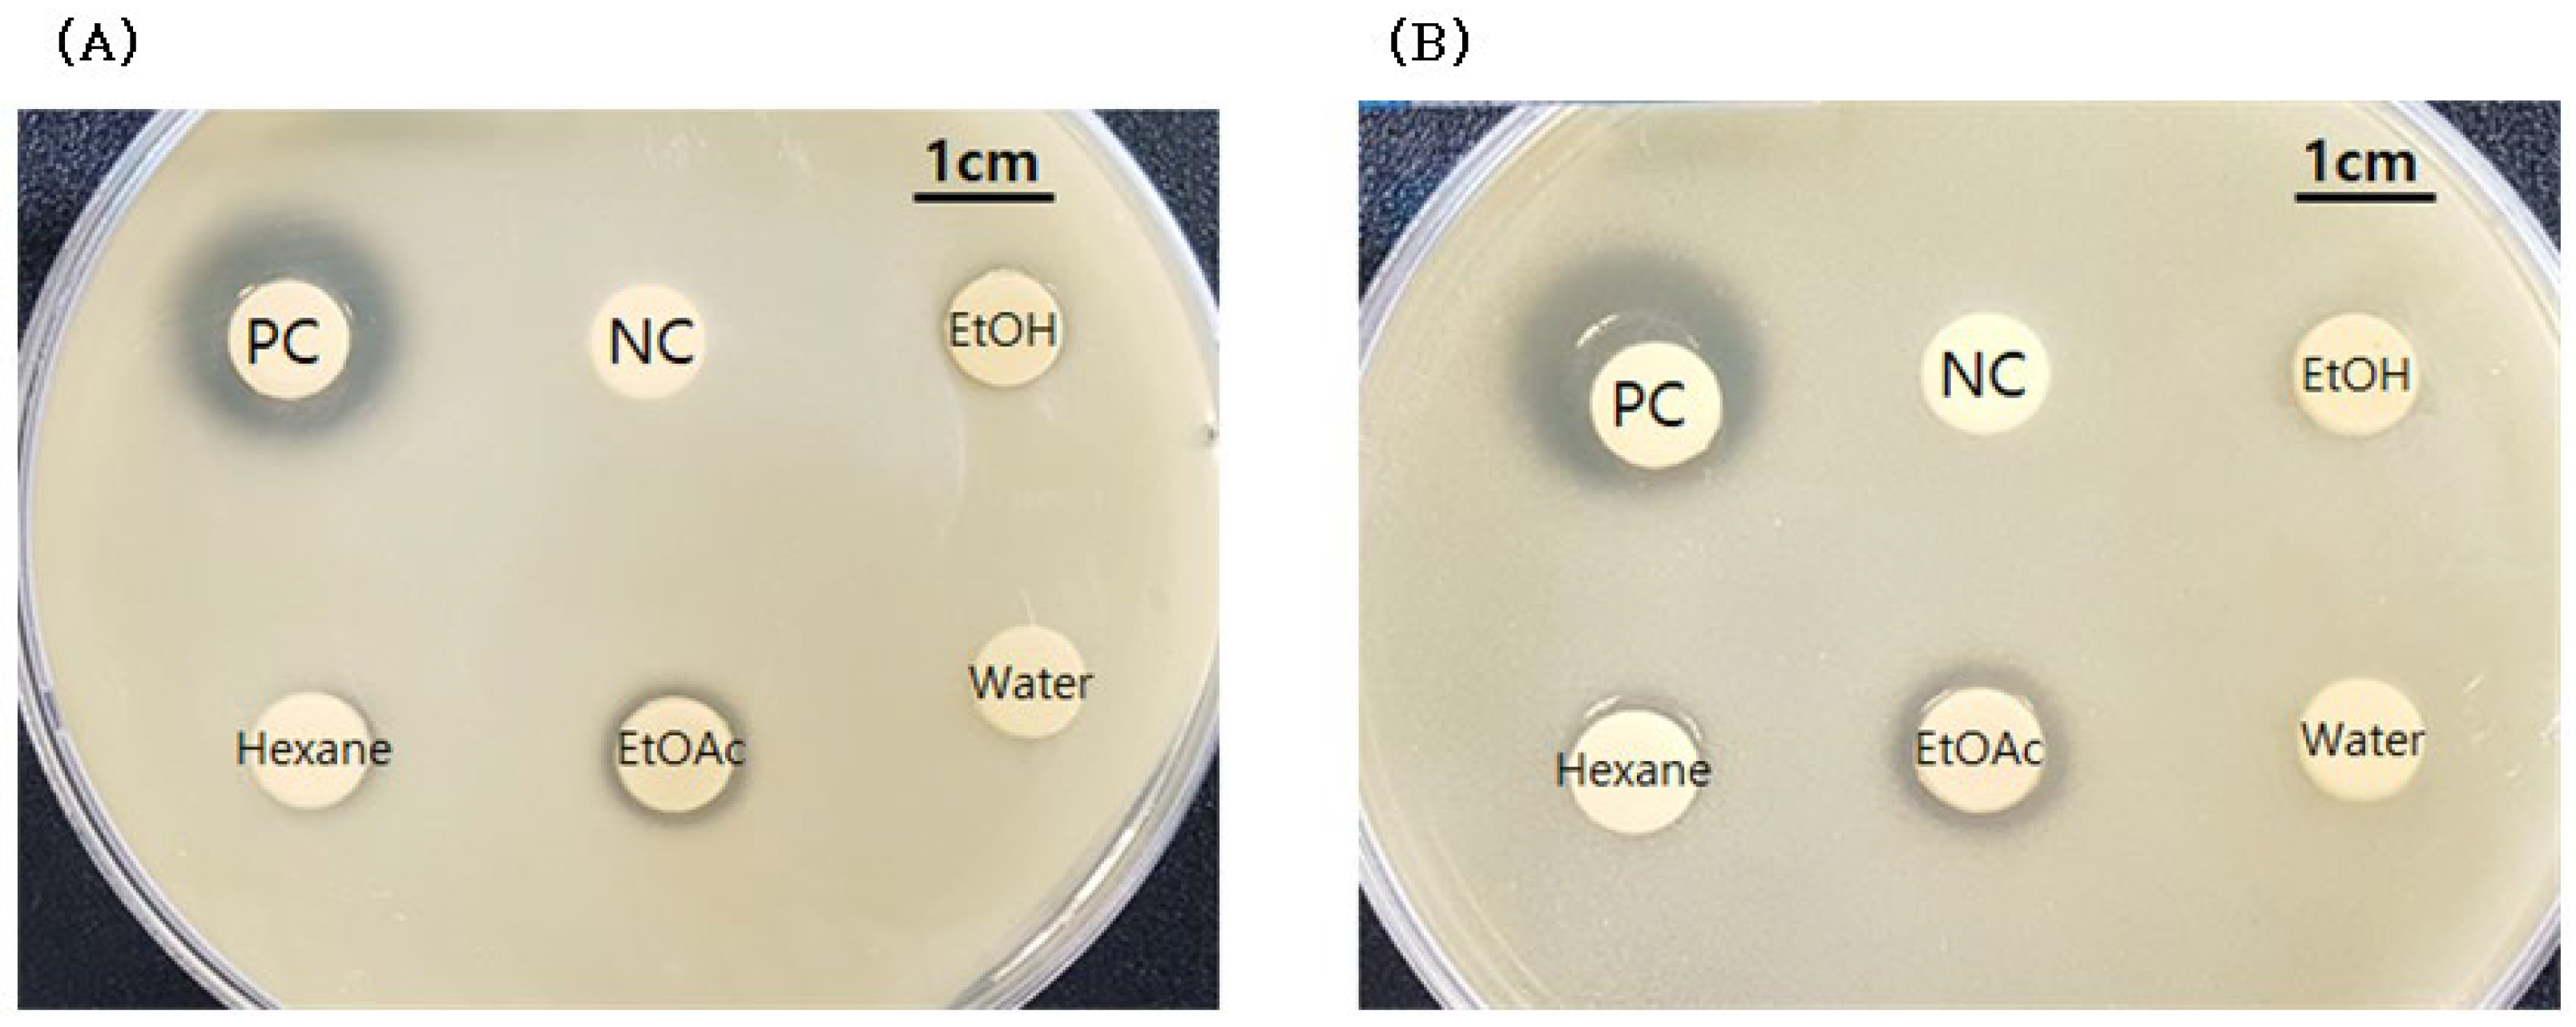
Molecules 27 08331 g001

Abstract
The root of Smilax china L. is used in traditional Korean medicine. We found that the Smilax china L. root extract has strong antimicrobial activity against two Cutibacterium acnes strains (KCTC 3314 and KCTC 3320). The aim of this study was to identify the beneficial properties of Smilax china L. extracts for their potential use as active ingredients in cosmetics for the treatment of human skin acne. The high-performance liquid chromatography (HPLC) and liquid chromatography-hybrid quadrupole time-of-flight mass spectrometry (LC/QTOF/MS) methods were used to obtain the profile of secondary metabolites from the ethyl acetate-soluble fraction of the crude extract. Agar diffusion and resazurin-based broth microdilution assays were used to evaluate antimicrobial activity and minimum inhibitory concentrations (MIC), respectively. Among the 24 metabolites, quercetin, resveratrol, and oxyresveratrol were the most potent compounds against Cutibacterium acnes. Minimum inhibitory concentrations of quercetin, resveratrol, and oxyresveratrol were 31.25, 125, and 250 μg/mL, respectively.
1. Introduction
Cutibacterium acnes is a Gram-positive bacterium that is usually found on the surface of human skin and is associated with acne vulgaris [1]. Acne vulgaris is a chronic inflammatory disease of the pilosebaceous unit, and acne bacteria live deep within follicles, pores, and on the surface of healthy skin [2,3]. Therefore, acne is one of the most common skin diseases, predominantly affecting adolescents and young adults. Prescriptions to treat acne are often for antibiotics such as clindamycin [4]; however, antibiotics sometimes cause side effects such as burning, itching, scaliness, and contact dermatitis [5,6]. An antiseptic, benzoyl peroxide, is effective for treating acne lesions and it does not induce antibiotic resistance. Common side effects of benzoyl peroxide [7] include redness, burning, and irritation [8]. A combination of clindamycin and benzoyl peroxide exists in the form of a topical gel used for the treatment of acne [9]; however, all formulations are prescription drugs that are not suitable for daily use products such as cosmetics. Natural products have been popular for decades for developing new cosmetics owing to the relatively high potency and low toxicity of traditional medicinal plants [10,11]. Recently, we found that the extract of Smilax china L. root effectively reduced the growth of C. acnes. Many secondary metabolites have been isolated from the medicinal plant, Smilax china [12,13]. For instance, stilbenes and flavonoids such as oxyresveratrol, resveratrol, and scirpusin A [14,15], steroidal saponins [16,17,18], and cytotoxic phenylpropanoid glycosides were isolated from Smilax china [19,20,21,22,23,24,25]. The new compounds, phenylpropanoid glycosides, isolated from the stems of Smilax china, are known smilasides [26]. In this study, to identify the active compounds from the crude extract of Smilax china, two different strains of C. acnes were tested on the fractions of crude extract and the pure compounds isolated from the fractions of the extract. The minimum inhibitory concentration (MIC) and minimum bactericidal concentration (MBC) of the isolated active compounds were tested against two C. acnes strains (KCTC 3314 and KCTC 3320).
2. Results
2.1. Antimicrobial Activity of Extract of Smilax china L. Root
Based on the agar diffusion method for antimicrobial activity, as shown in Figure 1, only the ethyl acetate soluble fraction of Smilax china L. root extract showed activity against Cutibacterium acnes KCTC 3314 (10.3 mm in diameter) and KCTC 3320 strains (11.8 mm), and this fraction was used for further analysis.
Figure 1.
Antimicrobial activity of fractions of Smilax china L. root extract. (A) Cutibacterium acnes KCTC 3314; (B) Cutibacterium acnes KCTC 3320. PC, positive control (Erythromycin, 5 μg/mL in DMSO); NC, negative control (DMSO, 100%); EtOH, ethyl alcohol-soluble fraction; Hexane, hexane-soluble fraction; EtOAc, ethyl acetate-soluble fraction; Water, water-soluble fraction of Smilax china L. root extract.
2.2. Analysis for Chemical Compositions of the Ethyl Acetate Fraction from Smilix china L. Root Crude Extract
First, the chemical compositions of the ethyl acetate fraction were investigated to reveal the major components of the mixture by using high-resolution liquid chromatography-hybrid quadrupole time-of-flight mass spectrometry (LC/QTOF/MS), as shown in Figure 2 and Table 1. Typical phytochemicals, such as organic acids and flavonoids, were identified from the exact mass of each isolated compounds and their theoretical mass. Stilbenoids, such as polydatin, oxyresveratrol, and resveratrol, were also found. The presence of quinic acid, caffeic acid, polydatin, quercetin, oxyresveratrol, catechin, and resveratrol was further confirmed by HPLC using standard compounds.
Figure 2.
LC/QTOF/MS chromatogram showing natural products from ethyl acetate-soluble fraction of Smilax china L. root extract.
Table 1.
Compounds identified from ethyl acetate-soluble fraction of Smilax china L. root extract.
Unique phenylpropanoid compounds, smilasides [26], were also detected using liquid chromatography-hybrid quadrupole time-of-flight mass spectrometry (LC/QTOF/MS). Peak 22 showed a quasi-molecular ion at m/z 777.2268 [M-H]−, which is consistent with the molecular formula C36H42O19 of smilaside A. Peak 23 shows a quasi-molecular ion at m/z 839.2405 [M-H]−, which is consistent with the theoretical exact mass 839.2399 of the molecular formula C41H44O19 of smilaside C. The detected mass of peak 24 is 881.2525, which is consistent with smilaside D or E, but we could not confirm exactly which one is D or E with only the mass result.
2.3. Antimicrobial Effect against Cutibacterium acnes of Fractions 1–5 Obtained from Silica Gel Column Chromatography
Fractions 1–5 of the crude extract were obtained using flash silica gel column chromatography with an eluent of 20% ethyl acetate in hexane as a starting point. The ethyl acetate content in the eluent was then gradually increased up to 50%. Fraction 1 obtained from the eluent with 20% ethyl acetate in hexane and fraction 2 obtained from the eluent with 50% ethyl acetate in hexane exhibited potent antimicrobial activity against C. acnes KCTC 3314 and KCTC 3320 strains, with the C. acnes KCTC 3314 strain being more susceptible to both fractions. The fractions 3, 4, and 5 obtained from flash column chromatography with eluents of 80% ethyl acetate in hexanes, 100% methylene chloride, and 20% methanol in methylene chloride did not show any antimicrobial activity against C. acnes, respectively.
Among the obtained fractions 1–5, only fractions 1 and 2 showed strong inhibition zones against C. acnes KCTC 3314 (22.3 and 21.3 mm, respectively) and C. acnes KCTC 3320 (13.3 and 12.0 mm, respectively), as shown in Figure 3. In particular, the inhibition zone diameters of fractions 1 and 2 against C. acnes KCTC 3314 were larger than those against C. acnes KCTC 3320.
Figure 3.
Antimicrobial activity of fractions from silica gel column chromatography to which ethyl acetate extract of Smilax china L. root was subjected. (A) C. acnes KCTC 3314; (B) C. acnes KCTC 3320. N, negative control (DMSO, 100%); Fractions 1~5, fractions from silica gel column chromatography.
2.4. Antimicrobial Effect of Isolated Compounds (Quercetin, Resveratrol, and Oxyresveratrol) against Cutibacterium acnes
Among the many identified compounds from the ethanolic extracts, three of them (quercetin, resveratrol, and oxyresveratrol) exhibited the strongest antimicrobial activity against two C. acnes strains (KCTC 3314 and KCTC 3320). The antimicrobial properties of compounds 13, 17, and 20 were assessed. The results revealed that the compounds 13, 17, and 20 efficiently suppressed the growth of C. acnes, which is involved in the pathogenesis of acne. Acne is a common skin disease and predominantly affects adolescents and young adults. The isolated compounds, quercetin, resveratrol, and oxyresveratrol, had strong inhibition zones against C. acnes KCTC 3314 (17.1, 26.5, and 21.4 mm) and C. acnes KCTC 3320 (12.3, 25.6, and 18.9 mm), respectively, as shown in Figure 4. Resveratrol showed the strongest antimicrobial activity against both C. acnes strains, as determined by the agar diffusion test.
Figure 4.
Antimicrobial effect of isolated compounds (Quer; quercetin, Res; resveratrol, and Oxy; oxyresveratrol) against C. acnes KCTC3314 (A) and C. acnes KCTC3320 (B).
Minimum inhibitory concentration (MIC) of the identified active compounds 13, 17, and 20 were measured using a resazurin assay. Minimum inhibitory concentration of quercetin, resveratrol, and oxyresveratrol were 31.25, 125, and 250 μg/mL, respectively. Quercetin is the most potent antimicrobial compound against C. acnes KCTC3314, as summarized in Table 2.
Table 2.
Minimum inhibition concentration (MIC) of active compounds 13, 17, and 20 against C. acnes KCTC 3314.
The minimum bactericidal concentrations (MBC) of compounds 13, 17, and 20 were measured. The MBCs of compounds 13, 17, and 20 were identical to their MICs, as listed in Table 3.
Table 3.
Minimum bactericidal concentration (MBC) of active compounds 13, 17, and 20 against C. acnes KCTC 3314.
2.5. Cytotoxicity of Compounds 3~5, 11, 13, 17, and 30
Seven compounds identified from Smilax china L. root were examined using the MTT assay to investigate their cytotoxic effect on skin cells. Quinic acid, quercetin, and catechin were not toxic to cells up to a concentration of 100 μg/mL. Resveratrol was also found in grapes [27,28] and showed mild cytotoxicity at a concentration of 20 μg/mL. Oxyresveratrol and caffeic acid were slightly more cytotoxic than resveratrol, which is one of the major components of the Smilax china L. root extract, based on the MTT assay. Overall, most of the metabolites of Smilax china L. root did not show any significant cytotoxicity up to 10 μg/mL. However, all MICs of Smilax china L. root crude extracts against C. acnes KCTC 3314 were 500 ppm. The mean percentage of the major active compound (resveratrol) contained in the dried Smilax china L. root extracts, was 0.35 wt% (our unpublished data). Therefore, final products are anticipated to contain approximately 1.75 ± 0.2 ppm (1.75 μg/mL) of resveratrol for anti-acne activity. Moreover, resveratrol did not show any cytotoxicity at the concentrations of approximately 5 ppm, as shown in Figure 5.
Figure 5.
Cell viability of each chemical on skin keratinocyte HaCaT cells. Cell viability was measured using the MTT assay described in Materials and Methods. Data are shown as mean ± SD and asterisks (*) indicate a significant inhibition by each compound compared with the untreated control group (*, p < 0.05 and **, p < 0.01).
3. Discussion
In this study, we investigated the antimicrobial properties of root extracts from Smilax china L. against C. acnes to determine the potential of this extract for cosmetic applications. A number of studies [12,13] have described the antibacterial properties of Smilax china L. leaves and root extracts. However, there is limited information on the use of Smilax china L. root extracts for biological applications in the cosmetic industry.
To identify the active compounds in the extract, the crude Smilax china L. extract was separated from an ethyl acetate–water mixture, fractionated by flash silica gel column chromatography, and purified by prep-HPLC. C. acnes KCTC3314 and 3320 strains were tested for anti-acne activity of fractionated mixtures. Preliminary experiments revealed that the crude Smilax china L. root extract had antimicrobial activity against both Gram-positive and Gram-negative bacteria (our unpublished data). Interestingly, crude Smilax china L. root extract demonstrated potent anti-acne activity against C. acnes as well.
The phenolic compounds found in Smilax china L. extracts are known to have varying antimicrobial activities. The synergic action, which has been observed for many phenolic compounds, can significantly enhance the antimicrobial effect [29]. Many polyphenolic compounds isolated from Smilax china L. have antimicrobial activity against bacteria such as Salmonella typhimurium, Listeria monocytogenes, Staphylococcus aureus, Bacillus subtilis, and Escherichia coli [12,25]. Interestingly, we found that only quercetin, one of many flavonoids isolated from Smilax china L. root extract, had a high antimicrobial effect against C. acnes, whereas two stillbenoid compounds, oxyresveratrol and resveratrol, had antimicrobial activity against C. acnes.
The antimicrobial activity and low toxicity of the extract make it suitable for a wide range of dermatological applications, including the treatment of acne vulgaris.
4. Materials and Methods
4.1. Materials
Smilax china L. root used in this study originated from Gyeongju city, Gyeongsangbuk-do, Korea and was supplied by Hwalim Natural Drug Co., Ltd. (Busan, Korea). C. acnes KCTC 3314 and KCTC3320 strains were purchased from the Korean Collection for Type Cultures (Jeongeup, Korea) and used for antimicrobial activity tests as human skin acne-causing bacteria. The solvents of Ethyl alcohol (95%), Methylene chloride, Ethyl acetate, n-Hexane, Methyl alcohol (99%), and Trifluoro acetic acid (TFA) were purchased from Samchun Chemical Co., Ltd. (Seoul, Korea). Acetonitrile and Formic acid were purchased from TEDIA (Fairfield, OH, USA) and Daejung Chemical Co. (Goryeong, Korea), respectively. Standard materials of (+)-Catechin hydrate, Chlorogenic acid crystalline, D-Quinic acid (98%), Caffeic acid, Oxyresveratrol, Resveratrol, Polydain, and Quercetin were purchased from Sigma-Aldrich, Inc. (St. Louis, MO, USA).
4.2. Preparation of Extract of Smilax china L. Root
To extract compounds, 100 g of Smilax china L. root powder was mixed with 95% ethanol in a round-bottom flask equipped with a mechanical stir for 12 h at 25 °C. The mixture was then concentrated to remove ethanol, and 8.40 g of powdered extract was obtained. In total, 8.40 g of the crude extract was treated with n-hexane and distilled water (50:50). The n-hexane layer was evaporated and concentrated (Yield, 2.69%). The water layer was separated with methylene chloride, ethyl acetate, and n-butanol, respectively. Ethyl acetate fraction was then dried over Na2SO4 and concentrated under reduced pressure to give 0.66 g (yield; 74.36% for water fraction and 7.89% for ethyl acetate fraction out of 8.40 g ethanol extract) of a sample as power for the UPLC/QTOF/MS analysis as shown in Figure 6.
Figure 6.
The flowchart of sample preparation.
4.3. High-Resolution UPLC/QTOF/MS Analysis
Ultra-performance LC/QTOF/MS analysis was performed on an ultra-high-resolution Q-TOF LC-MS/MS system (Micro QTOF III, Bruker Daltonix Gmbh, Bremen, Germany.) using a C18 column (Ace 3 C18-300), with a particle size of 1.7 mm, dimensions of 2.1 mm × 125 mm, and flow rate of 0.4 mL min−1, and an electrospray ionization (ESI) source. The eluent solvents consisted of 0.1% formic acid in water (eluent A) and 0.1% formic acid in acetonitrile (eluent B). The mobile phase consisted of (A) and (B) with a gradient elution of 0–55% B at 0–30 min and 55–95% B at 30–40 min.
4.4. HPLC Analysis
The extracts were analyzed by high-performance liquid chromatography (HPLC, YL 9112S) equipped with PDA detector and a reverse-phase C18 column (Kinetex, 4.6 mm × 250 mm, 5 μm, 100 Å). The flow rate applied was 1.0 mL/min. Pure compounds were isolated with prep-HPLC equipped with a reverse-phase C18 column (YMC-Triart, 10 mm × 250 mm, 5 μm, 12 nm) and the flow rate applied was 2.5 mL/min. The eluent solvents consisted of 0.1% trifluoroacetic acid in water (eluent A) and 0.1% trifluoroacetic acid in acetonitrile (eluent B). The mobile phase consisted of (A) and (B) with a gradient elution of 0–25% B at 0–30 min, and 25–45% B at 30–40 min. The detection wavelengths were set at 220 and 300 nm.
4.5. Preliminary Antimicrobial Activity
The agar diffusion method was used to confirm the antibacterial activity of Smilax china L. root extract (conc. 10 mg/mL of DMSO), its fractions (conc. 10 mg/mL of DMSO), and pure components (conc. 10 mg/mL of DMSO) including resveratrol, oxyresveratrol, and quercetin against acne-causing C. acnes [30]. C. acnes KCTC 3314 and KCTC 3320, which are strictly anaerobic bacteria, were cultured in RCM broth (BD, Sparks, MD, USA) in an anaerobic jar (Oxford, Cambridge, UK) with GasPaK™ (BD). The culture was inoculated in RCM soft agar (0.7% agar, w/v) and poured onto an RCM agar plate. Disc paper with 20 μL of each sample (0.2 mg/disc) was loaded on the plates and incubated at 37 °C for 24 h, anaerobically described above and inhibition zones around discs were examined.
4.6. Determination of Minimum Inhibitory Concentrations and Minimum Bactericidal Concentration
To measure minimum inhibitory concentration (MIC) of antimicrobial compounds including resveratrol, oxyresveratrol, and quercetin, a resazurin assay was performed as per a previous study with modifications, since DMSO, the solvent for the compounds, was toxic to C. acnes KCTC 3314 and the limited volume of diluted samples in DMSO was acceptable not to inhibit its growth [31]. Namely, in 96-well microplates, 20 µL of 106 CFU/mL of C. acnes KCTC 3314 was inoculated in 176 µL of RCM broth to be 105 CFU/mL in the final volume of 200 µL and each 4 µL of serially 2-fold diluted sample in DMSO, which ranged from 1000 to 7.8125 ppm in the final volume and was added in triplicates. The microplate was incubated at 37 °C for 24 h in an anaerobic jar (Oxford, UK) with GasPaK™ (BD). After incubation, 20 µL of resazurin (1 mg/mL) were added to each well of the microplate and incubated at 37 °C for 4 h in an orbital shaker with 100 rpm for resazurin metabolization. Then, the color change was examined. MIC was determined as the lowest concentration where the color was not changed. To determine minimum bactericidal concentration (MBC), the above diluents for MIC test were used. The volume of two microliters from each diluent was plated on a RCM agar plate. The MBC was determined by the lowest concentration of compound at which no bacterial colony of C. acnes KCTC 3314 was shown on the plate, which means the MBC value reduced initial viable cell counts by ≥99.9% [32,33,34].
4.7. Cell Viability Assay
Cell viability of HaCaT cells was determined by an MTT assay [35,36]. HaCaT cells were cultured in the 96-well plates at 5.0 × 104 cells per wells and incubated in completed DMEM. Cells were starved in serum-free DMEM for 12 h. After serum-starvation, the cells were incubated with different concentrations of each chemical. After the addition of MTT solution (10% v/v) in serum-free DMEM, the cells were incubated for 1 h. The medium was removed and dimethyl sulfoxide (DMSO) was added to each well to dissolve formazan crystals. The absorbance at 570 nm was measured using a microplate reader.
5. Conclusions
Taken together, we successfully extracted components from the roots of Smilax china L. and studied them against Gram-positive C. acnes strains, which are involved in skin diseases such as acne. Based on UPLC/QTOF/MS and silica gel column chromatography, three active components were selected, quercetin, resveratrol, and oxyresveratrol. The components showed strong inhibition zones against C. acnes KCTC 3314 and KCTC 3320 strains. Among these components, resveratrol greatly inhibited the growth of both strains followed by oxyresveratrol and quercetin, respectively. However, quercetin showed the lowest MIC and MBC values of 31.25 ug/mL against C. acnes KCTC 3314 strain and was found to have lower cytotoxic activity compared with resveratrol and oxyresveratrol. To the best of our knowledge, this is the first study to identify the active ingredients of Smilax china L. root extracts and investigate their antibacterial effects against C. acnes.
To further investigate the potential of Smilax china L. root extracts for cosmetic applications, various types of cosmetic products need to be produced and tested for clinical trials in the near future.
Author Contributions
Conceptualization, G.-S.M., H.-Y.L., H.S.O. and J.D.L.; methodology, Y.S.C., K.-H.J., and H.J.A.; formal analysis, J.-H.J.; investigation, J.-H.J., J.-I.K., M.-H.H. and J.-E.K.; resources, H.J.A.; writing—original draft preparation, G.-S.M. and H.-Y.L.; writing—review and editing, H.-Y.L.; supervision, G.-S.M. and H.-Y.L.; project administration, G.-S.M. and H.-Y.L.; funding acquisition, G.-S.M. and H.-Y.L. All authors have read and agreed to the published version of the manuscript.
Funding
This research was partly supported by the technology development program of MSS (S2952823) and the Basic Science Research Program through the National Research Foundation of Korea (NRF), funded by the Ministry of Education (No. 2021R1A6A1A03046418).
Institutional Review Board Statement
Not applicable.
Informed Consent Statement
Not applicable.
Data Availability Statement
Date are available on request from the corresponding author.
Acknowledgments
We would like to thank Editage (www.editage.co.kr) for English language editing.
Conflicts of Interest
The authors declare no conflict of interest.
Sample Availability
Samples of the compounds are not available from the authors.
References
- Dreno, B.; Pecastaings, S.; Corvec, S.; Veraldi, S.; Khammari, A.; Roques, C. Cutibacterium acnes (Propionibacterium acnes) and acne vulgaris: A brief look at the latest updates. J. Eur. Acad. Dermatol. Venereol. 2018, 32 (Suppl. S2), 5–14. [Google Scholar] [CrossRef]
- Aslam, I.; Fleischer, A.; Feldman, S. Emerging drugs for the treatment of acne. Expert Opin. Emerg. Drugs 2015, 20, 91–101. [Google Scholar] [CrossRef] [PubMed]
- Knutsen-Larson, S.; Dawson, A.L.; Dunnick, C.A.; Dellavalle, R.P. Acne vulgaris: Pathogenesis, treatment, and needs assessment. Dermatol. Clin. 2012, 30, 99–106. [Google Scholar] [CrossRef]
- Ross, J.I.; Snelling, A.M.; Carnegie, E.; Coates, P.; Cunliffe, W.J.; Bettoli, V.; Tosti, G.; Katsambas, A.; Galvan Perez Del Pulgar, J.I.; Rollman, O.; et al. Antibiotic-resistant acne: Lessons from Europe. Br. J. Dermatol. 2003, 148, 467–478. [Google Scholar] [CrossRef] [PubMed]
- Habeshian, K.A.; Cohen, B.A. Current Issues in the Treatment of Acne Vulgaris. Pediatrics 2020, 145, S225–S230. [Google Scholar] [CrossRef]
- Sevimli Dikicier, B. Topical treatment of acne vulgaris: Efficiency, side effects, and adherence rate. J. Int. Med. Res. 2019, 47, 2987–2992. [Google Scholar] [CrossRef]
- Leyden, J.J.; Wortzman, M.; Baldwin, E.K. Antibiotic-resistant Propionibacterium acnes suppressed by a benzoyl peroxide cleanser 6%. Cutis 2008, 82, 417–421. [Google Scholar] [PubMed]
- Lubtikulthum, P.; Kamanamool, N.; Udompataikul, M. A comparative study on the effectiveness of herbal extracts vs 2.5% benzoyl peroxide in the treatment of mild to moderate acne vulgaris. J. Cosmet. Dermatol. 2019, 18, 1767–1775. [Google Scholar] [CrossRef] [PubMed]
- McKeage, K.; Keating, G.M. Clindamycin/benzoyl peroxide gel (BenzaClin): A review of its use in the management of acne. Am. J. Clin. Dermatol. 2008, 9, 193–204. [Google Scholar] [CrossRef]
- Emrich, S.; Schuster, A.; Schnabel, T.; Oostingh, G.J. Antimicrobial Activity and Wound-Healing Capacity of Birch, Beech and Larch Bark Extracts. Molecules 2022, 27, 2817. [Google Scholar] [CrossRef]
- Kim, E.; Kim, D.; Yoo, S.; Hong, Y.H.; Han, S.Y.; Jeong, S.; Jeong, D.; Kim, J.H.; Cho, J.Y.; Park, J. The skin protective effects of compound K, a metabolite of ginsenoside Rb1 from Panax ginseng. J. Ginseng. Res. 2018, 42, 218–224. [Google Scholar] [CrossRef] [PubMed]
- Xu, M.; Xue, H.; Li, X.; Zhao, Y.; Lin, L.; Yang, L.; Zheng, G. Chemical composition, antibacterial properties, and mechanism of Smilax china L. polyphenols. Appl. Microbiol. Biotechnol. 2019, 103, 9013–9022. [Google Scholar] [CrossRef] [PubMed]
- Xu, Y.; Zhang, N.; Xiong, L.; Sun, D.; Chen, Z.; Chen, L. A new phenylpropanoid-substituted epicatechin from the rhizome of Smilax china. Nat. Prod. Res. 2022, 36, 1–9. [Google Scholar] [CrossRef] [PubMed]
- Kim, J.H.; Park, T.S.; Yang, S.H.; Suh, J.W.; Shim, S.M. Microbial bioconversion and processing methods enhance the phenolic acid and flavonoids and the radical scavenging capacity of Smilax china L. leaf. J. Sci. Food Agric. 2016, 96, 878–885. [Google Scholar] [CrossRef] [PubMed]
- Shao, B.; Guo, H.Z.; Cui, Y.J.; Liu, A.H.; Yu, H.L.; Guo, H.; Xu, M.; Guo, D.A. Simultaneous determination of six major stilbenes and flavonoids in Smilax china by high performance liquid chromatography. J. Pharm. Biomed. Anal. 2007, 44, 737–742. [Google Scholar] [CrossRef]
- Sashida, Y.; Kubo, S.; Mimaki, Y.; Nikaido, T.; Ohmoto, T. Steroidal saponins from Smilax riparia and S. china. Phytochemistry 1992, 31, 2439–2443. [Google Scholar] [CrossRef]
- Shao, B.; Guo, H.; Cui, Y.; Ye, M.; Han, J.; Guo, D. Steroidal saponins from Smilax china and their anti-inflammatory activities. Phytochemistry 2007, 68, 623–630. [Google Scholar] [CrossRef]
- Tian, L.W.; Zhang, Z.; Long, H.L.; Zhang, Y.J. Steroidal Saponins from the Genus Smilax and Their Biological Activities. Nat. Prod. Bioprospect 2017, 7, 283–298. [Google Scholar] [CrossRef]
- Feng, H.; He, Y.; La, L.; Hou, C.; Song, L.; Yang, Q.; Wu, F.; Liu, W.; Hou, L.; Li, Y.; et al. The flavonoid-enriched extract from the root of Smilax china L. inhibits inflammatory responses via the TLR-4-mediated signaling pathway. J. Ethnopharmacol. 2020, 256, 112785. [Google Scholar] [CrossRef]
- Huang, H.; Zhang, J.; Chen, G.; Lu, Z.; Wang, X.; Sha, N.; Shao, B.; Li, P.; Guo, D.A. High performance liquid chromatographic method for the determination and pharmacokinetic studies of oxyresveratrol and resveratrol in rat plasma after oral administration of Smilax china extract. Biomed. Chromatogr. 2008, 22, 421–427. [Google Scholar] [CrossRef]
- Jiang, S.; Wei, Q.; Ye, X.; Luo, D.; Zhang, X.; Li, Z.; You, P.; Huang, X.; Liu, Y. The Anti-Inflammatory Effect of Smilax china L. Extract on LPS-Stimulated THP-1 via Downregulation of MAPK and NF-kappaB Signaling Pathway. Evid. Based Complement Altern. Med. 2021, 2021, 9958808. [Google Scholar] [CrossRef] [PubMed]
- Jiang, S.Y.; Song, X.Y.; Zhang, D.D.; Li, Z.L.; Yang, Y.Y.; Luo, X.Y.; Ye, X.C. Spectrum-effect relationship between UPLC fingerprint of Smilax china and anti-pelvic inflammation in rats. Zhongguo Zhong Yao Za Zhi 2019, 44, 3323–3329. [Google Scholar] [CrossRef] [PubMed]
- Kong, L.; Zhang, W.; Liu, S.; Zhong, Z.; Zheng, G. Quercetin, Engelitin and Caffeic Acid of Smilax china L. Polyphenols, Stimulate 3T3-L1 Adipocytes to Brown-like Adipocytes Via beta3-AR/AMPK Signaling Pathway. Plant Foods Hum. Nutr. 2022, 77, 529–537. [Google Scholar] [CrossRef]
- Lee, H.E.; Kim, J.A.; Whang, W.K. Chemical Constituents of Smilax china L. Stems and Their Inhibitory Activities against Glycation, Aldose Reductase, alpha-Glucosidase, and Lipase. Molecules 2017, 22, 451. [Google Scholar] [CrossRef] [PubMed]
- Shu, X.S.; Gao, Z.H.; Yang, X.L. Supercritical fluid extraction of sapogenins from tubers of Smilax china. Fitoterapia 2004, 75, 656–661. [Google Scholar] [CrossRef] [PubMed]
- Kuo, Y.H.; Hsu, Y.W.; Liaw, C.C.; Lee, J.K.; Huang, H.C.; Kuo, L.M. Cytotoxic phenylpropanoid glycosides from the stems of Smilax china. J. Nat. Prod. 2005, 68, 1475–1478. [Google Scholar] [CrossRef]
- Fan, E.; Zhang, K.; Jiang, S.; Yan, C.; Bai, Y. Analysis of trans-resveratrol in grapes by micro-high performance liquid chromatography. Anal. Sci. 2008, 24, 1019–1023. [Google Scholar] [CrossRef][Green Version]
- Gescher, A.J. Resveratrol from red grapes—Pedestrian polyphenol or useful anticancer agent? Planta Med. 2008, 74, 1651–1655. [Google Scholar] [CrossRef]
- Rempe, C.S.; Burris, K.P.; Lenaghan, S.C.; Stewart, C.N., Jr. The Potential of Systems Biology to Discover Antibacterial Mechanisms of Plant Phenolics. Front. Microbiol. 2017, 8, 422. [Google Scholar] [CrossRef]
- Yang, J.M.; Moon, G.S. Partial Characterization of an Anti-Listerial Bacteriocin from Enterococcus faecium CJNU. Food Sci. Anim. Res. 2021, 41, 164–171. [Google Scholar] [CrossRef]
- Teh, C.H.; Nazni, W.A.; Nurulhusna, A.H.; Norazah, A.; Lee, H.L. Determination of antibacterial activity and minimum inhibitory concentration of larval extract of fly via resazurin-based turbidometric assay. BMC Microbiol. 2017, 17, 36. [Google Scholar] [CrossRef] [PubMed]
- Qureshi, K.A.; Mohammed, S.A.A.; Khan, O.; Ali, H.M.; El-Readi, M.Z.; Mohammed, H.A. Cinnamaldehyde-Based Self-Nanoemulsion (CA-SNEDDS) Accelerates Wound Healing and Exerts Antimicrobial, Antioxidant, and Anti-Inflammatory Effects in Rats’ Skin Burn Model. Molecules 2022, 27, 5225. [Google Scholar] [CrossRef] [PubMed]
- Mohammed, H.A.; Al-Omar, M.S.; Khan, R.A.; Mohammed, S.A.A.; Qureshi, K.A.; Abbas, M.M.; Al Rugaie, O.; Abd-Elmoniem, E.; Ahmad, A.M.; Kandil, Y.I. Chemical Profile, Antioxidant, Antimicrobial, and Anticancer Activities of the Water-Ethanol Extract of Pulicaria undulata Growing in the Oasis of Central Saudi Arabian Desert. Plants 2021, 10, 1811. [Google Scholar] [CrossRef] [PubMed]
- Mohammed, H.A.; Ali, H.M.; Qureshi, K.A.; Alsharidah, M.; Kandil, Y.I.; Said, R.; Mohammed, S.A.A.; Al-Omar, M.S.; Rugaie, O.A.; Abdellatif, A.A.H.; et al. Comparative Phytochemical Profile and Biological Activity of Four Major Medicinal Halophytes from Qassim Flora. Plants 2021, 10, 2208. [Google Scholar] [CrossRef] [PubMed]
- Byeon, H.J.; Jung, K.H.; Moon, G.S.; Moon, S.K.; Lee, H.Y. A facile and efficient method for the synthesis of crystalline tetrahydro-beta-carbolines via the Pictet-Spengler reaction in water. Sci. Rep. 2020, 10, 1057. [Google Scholar] [CrossRef] [PubMed]
- Marks, D.C.; Belov, L.; Davey, M.W.; Davey, R.A.; Kidman, A.D. The MTT cell viability assay for cytotoxicity testing in multidrug-resistant human leukemic cells. Leuk. Res. 1992, 16, 1165–1173. [Google Scholar] [CrossRef]
Publisher’s Note: MDPI stays neutral with regard to jurisdictional claims in published maps and institutional affiliations. |
© 2022 by the authors. Licensee MDPI, Basel, Switzerland. This article is an open access article distributed under the terms and conditions of the Creative Commons Attribution (CC BY) license (https://creativecommons.org/licenses/by/4.0/).